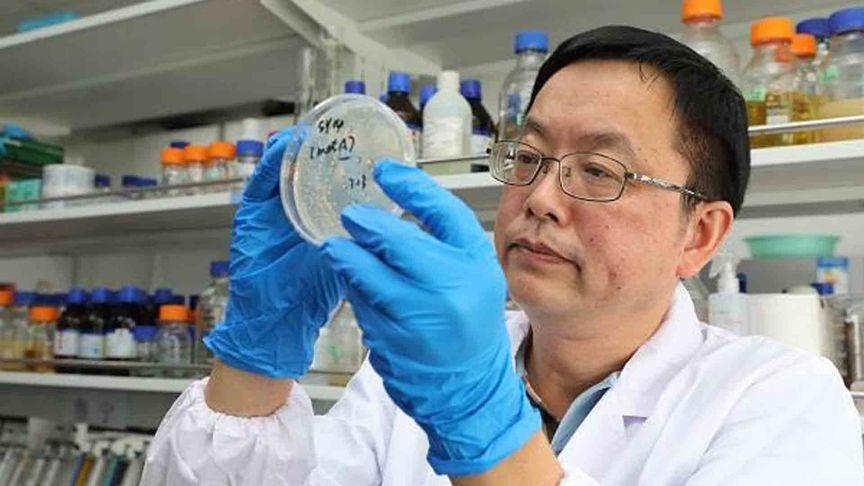

現在的中國爲什麼很難出科學家?到底是什麼原因造成的呢?
我國著名的科學家錢學森曾經提出過一個著名的問題,中國爲什麼很難再出科學家?這裏的科學家是指大師,中國很難出現轟動世界的大師,很多行業,難以出現轟動一時的,具有重大貢獻的專業翹楚,這到底是什麼原因造成的呢?

現在的中國,根本不缺少財務物力,還具有科研的優越條件,爲什麼反而難以湧現出優秀的人才呢?雖然我國的各行業專家學者和專業的科研人員數量也不算少,但是想要有聞名世界的大師,卻非常不容易。
很多專業的學者認爲,我國的科學家之所以不能出現大師,其實和創新思想,打破框架思維的能力,都有一定的關係。

中國人的智慧是不用質疑,但是在打破常規的創新方面,還有一些侷限,因爲很多人接受的教育都是要整齊劃一,甚至很多人認爲,不能隨大流和不能和別人一樣,恐怕被別人看做是異類或者別出心裁,很多人都不習慣被認爲不合羣,也不願意表現出和別人不同。
因此,這樣的中庸思想,就讓很多人甚至把銳意進取的想法,以及一些別有洞天的觀點,隱藏起來,最後銳氣消散,或許就此泯於衆人。

當然這樣的觀點作爲一種看法,也有一定的道理,但是不能否認的是,我國也有優秀的人才,也有通過勤奮苦讀,開創行業新局面的科學家和專業人才,這些人的才華和貢獻,也是可圈可點,爲我國的多個領域都做出了不可埋沒的貢獻。
國家其實大力提倡要培養科技和科研人才,也爲此投入很多經費和成本,但是不能否認的是,在一些優秀的人才得到遴選和培養的同時,也有一些個別的讓人遺憾和惋惜的情況。比如一些學術和專業水平的評比,可能競爭環境和所處的位置,不能做到真正的公平,真正有才華的人,最優秀的人,或許會因爲人情世故不夠練達,錯失能夠繼續提升的通道。因此很多專心搞科研的人,爲了人際環境更加簡單,就選擇走出去,我國也因此流失了一部分人才。

能夠在科研方面,做出廢寢忘食研究的學者,確實無法分心去做八面玲瓏的交際達人,其實這種情況,並不是不存在,很多人也都清楚,畢竟我們的文化,就是一個講究人情世故的文化背景,也有着一些人情難卻的默認規則。
而在某些特殊的情況下,可能就有更會表達的人,得到了更爲稀少的機會,因此讓更適合做科研的人,反而失去了能夠安心研究的機會。
中國綜合國力強大,爲什麼卻出不了大師級的科學家了?
現在的科研環境,並不缺少資金和研發的條件,按照我國著名學者在美國大學交流後的心得,認爲美國的斯坦福大學,只在最近兩年間,就有四位教授獲得諾貝爾獎項,可見美國的科學家的研究成果,是受到國家矚目。
斯坦福的建校時間只有120年左右,卻培養出多位獲得國際大獎的科研精英,涉及的領域也是非常寬泛。在教師隊伍中,都有30多人獲得過諾獎,這樣龐大而震撼的師資專業力量,讓國際社會都驚歎不已。

按照我國學者在斯坦福大學一年時間的觀察和了解,認爲這所大學的學術研究者,無論生物,化學,物理,任何領域,都致力於專心致志地思考自己研究的課題。
而且關注的都是前沿尖端的課題,學術氛圍濃厚而嚴謹,熱烈的討論和爭論的氛圍,激發很多不同思想的碰撞,讓學生的探究和好奇,都能得到尊重和鼓勵,關於學術的講座和交流,舉辦的頻次非常高,這些人都在醉心研究自己的課題,學習和研究,很少看到和聽到有人關注和交流學術之外的問題。

而這一個重點,就能看出極大的不同,去看看其他大學的人們都在討論什麼是否能激烈爭論學術觀點,就知道學術的進步和前沿科技的騰飛能力,區別也許在於對學術探索的單純和執着的生態環境。
也許這是一個非常不同的氛圍所在,也是很多科學課題,能夠有更好的思維跳脫瓶頸桎梏的更快的方式。

而且教育背景和追求目標的不同,在學術領域面對不同研發觀點和分歧時,在面對課題之外,還要考慮表達不同意見的附加影響,這些隱形的壓力和因素,自然也是對科研生態系統的單一情況,有所影響的原因。
也許這些綜合因素,也是一些原因所在。

















